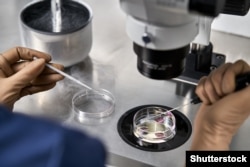

В 1978 году англичанка Луиза Браун стала первым человеком в мире, рожденным в результате экстракорпорального оплодотворения.
Процедура ЭКО заключается в том, что яйцеклетку извлекают из организма и оплодотворяют искусственно, эмбрион содержат в условиях инкубатора, где он развивается в течение 2–5 дней, после чего его переносят в матку. В конце 70-х это было сенсацией, и мать Луизы Браун, да и ее саму преследовали репортеры. Сегодня ЭКО – обыденность, миллионы людей родились с помощью этой репродуктивной технологии, и ее возможности постоянно расширяются. Функционируют специальные клиники, открыты банки спермы, можно воспользоваться услугами суррогатных матерей, к ЭКО прибегают и знаменитости, и скромные обыватели.
В самом ли деле близка эпоха, когда на место отца и матери придут "родитель номер один" и "родитель номер два"?
Но далеко не всем бесплодным матерям удается зачать при помощи ЭКО, и тем более не всем удается сделать это с первого раза. Три года назад журналист Инна Денисова сняла документальный фильм "Порочное незачатие" о том, как она пыталась забеременеть при помощи ЭКО в клиниках России и Казахстана. Все попытки закончились неудачей. Ребенок так и не родился, но появилась книга "Сделай меня точно", в которой Инна Денисова описывает историю новых репродуктивных технологий. Читатель познакомится с рассказами счастливых матерей, узнает об отношении к ЭКО в разных странах и обнаружит, как много вопросов – юридических, религиозных, этических – порождает эта процедура. Где-то ЭКО разрешено для всех, где-то ограничено, где-то запрещено. Есть страны, в которых процедуру оплачивает государство, в других она покрывается медицинской страховкой, а где-то придется раскошелиться будущим родителям. Разные цены, разные условия, разные возможности.
Этично ли нанимать нуждающихся женщин в качестве суррогатных матерей? Можно ли использовать яйцеклетки и сперму покойников? Как могут завести детей однополые пары? Реально ли менять гены ребенка, чтобы он родился таким, каким его мечтают видеть родители? Следует ли скрывать имя донора или он имеет право встречаться с зачатыми при помощи его биоматериалов людьми? Как развивается "сородительство", когда люди договариваются о рождении ребенка, не вступая в близкие отношения? Можно ли освободить женщину от необходимости вынашивать детей и заменить ее искусственной маткой? В самом ли деле близка эпоха, когда на место отца и матери придут "родитель номер один" и "родитель номер два"? Эти вопросы звучат в книге "Сделай меня точно" и в программе Радио Свобода "Культурный дневник", гостем которой была Инна Денисова.
– Инна, вы называете ЭКО локомотивом, тянущим мир в будущее. Наверное, кого-то такое определение удивит, ведь речь идет, казалось бы, всего лишь о бесплодии, проблеме, с которой большинство людей не знакомы. Вы посвящаете футурологии последнюю главу книги, а я предлагаю с нее начать разговор. Как техники, которые вы описываете, изменят мир?
ЭКО – это способ заводить детей, когда ты хочешь и с кем ты хочешь
– Мир уже изменился. Начать хотя бы с того, что в больших городах люди уже совсем не стремятся рожать не то, что в 20, а и в 30–35 тоже. Мысли о первом ребенке приходят ближе к сорока. Соответственно, речь не только бесплодии, но и об отложенном родительстве, более удобной модели родительства. Есть разные семьи – из одного человека, из двух однополых людей. Соответственно, ЭКО – это не только способ лечения бесплодия, но также способ заводить детей, когда ты хочешь и с кем ты хочешь.
– Читатель узнает из вашей книги, что ребенка может родить мужчина-трансгендер, отцом может стать мертвец и у ребенка могут быть гены нескольких человек, не только его биологических родителей.
– Помню, как я удивилась, когда впервые услышала про посмертную репродукцию. Двое готовятся стать родителями, замораживают эмбрионы, а потом один умирает. Что тогда делает другой? Он может, если это отец, взять суррогатную мать, и ребенок родится после смерти матери. Либо женщина может подсадить себе этот эмбрион и родить ребенка после смерти отца. Если трансгендерные люди сохранят репродуктивные органы, то они могут выносить и родить. Со смешиванием генов разных людей врачи пока экспериментируют, и не факт, что это в итоге будет разрешено. В книге я описываю одну такую технологию, митохондриальную заместительную терапию, когда у женщины не хватает митохондрий в яйцеклетках и она берет донорские: соответственно, у эмбриона будут гены двух женщин. С этой процедурой врачи сейчас экспериментируют. Думаю, в будущем она будет распространяться больше.
– Много поразительных вещей я узнал из вашей книги. Например, о том, что в Новой Зеландии существует банк спермы ВИЧ-позитивных людей.
– Это сделано для дестигматизации ВИЧ-инфицированных людей, проект инициирован благотворительными организациями. Донором может стать человек с так называемой "неопределяемой вирусной нагрузкой", то есть вирус не передается его потомству.
– Можно сказать, что вся эта история – о вызове, который брошен патриархальному обществу. Вы посвящаете немало страниц описанию того, как патриархат в лице консервативных государственных органов и в лице церкви борется с теми, кто пытается зачать и родить ребенка не так, как это делали тысячу лет назад. Там есть драматические случаи, когда репрессивные механизмы мешают потенциальным родителям завести детей. Расскажите, пожалуйста, о том, как патриархат наносит удар по современности.
Так называемые "традиционные установки" приносят женщинам много вреда
– У каждого из нас найдутся знакомые, которые скажут "пусть дети рождаются так, как это задумано природой" (хотя в своей книге я цитирую антропологов, утверждающих, что никакого замысла природы не существует). Так называемые "традиционные установки" приносят женщинам много вреда. В Италии, например, долго было запрещено консервировать эмбрионы, ведь эмбрион может погибнуть в процессе разморозки, а это якобы уже человек. Соответственно, если у женщины на ЭКО получилось 8 эмбрионов, то она должна пересадить все восемь. В результате возникали многоплодные беременности, когда в процессе приходилось делать редукцию, убивать неправильно развивающийся плод. Италия – католическая страна, а католицизм сопротивляется ЭКО, даже мусульманство относится к процедуре гораздо мягче.
– А буддизм еще мягче.
– Буддизм принимает все, от чего человеку становится хорошо, что облегчает страдания и не вредит окружающим.
– Меня поразило описание практик в Иране. Известная вещь, что шииты могут заключить брак на одну ночь, это старая традиция, но раньше это был способ легитимизировать проституцию или адюльтеры. Здесь это делается для того, чтобы зачать ребенка.
Заключить краткосрочный брак с донором, взять сперму или яйцеклетку, потом развестись
– Мусульманам очень важно иметь детей. Если детей нет, женщину будут считать неполноценной, семья будет несчастной. Религия внушает людям, что счастье невозможно без продолжения рода. Сначала и сунниты, и шииты, разрешая ЭКО, сопротивлялись донорству, то есть участию в процессе зачатия третьих лиц. Однако в некоторых случаях ребенка по-другому завести невозможно: при мужском бесплодии нужна донорская сперма, при отсутствии яйцеклеток нужны донорские. Тогда шииты придумали, как обойти фетву, запрещающую донорство: заключить краткосрочный брак с донором, взять сперму или яйцеклетку, потом развестись, и снова жениться уже на том, с кем будешь этих детей воспитывать.
– Это, конечно, увлекательно, но вряд ли наши читатели отправятся в Иран, чтобы заключать брак на одну ночь. Как обстоят дела в России? Ведь тоже достаточно либеральное законодательство, но не всегда, есть и трагические истории.
– Россия, с одной стороны, наследница советских социалистических традиций, а с другой – хищного капитализма. В России все продается и покупается. Есть огромное количество ЭКО-клиник, ради процветания их бизнеса принят закон, разрешающий суррогатное материнство. Одновременно сегодняшняя Россия – страна без социальных лифтов. Для женщины из маленького города суррогатное материнство – единственная возможность изменить жизнь, дать детям шанс получить образование или отремонтировать квартиру.
– Были и случаи недавно, когда в Москве младенцев конфисковали у суррогатных матерей, вынашивавших их для филиппинских заказчиков. Эта история продолжается?
Карающее российское правосудие пожирает детей
– Да, она, к сожалению, продолжается. Есть версия: младенцев конфисковали потому, что полицейские не разобрались, что такое суррогатное материнство или донорские яйцеклетки, и они не знают, что все это разрешает российский закон. Дело там было в следующем. В одной из квартир, снятых сурагентством, где младенцы, в ожидании оформления документов, находились под присмотром няни, умер ребенок. Этот ребенок родился с диагнозом, несовместимым с жизнью: не очень понятно, почему его в принципе выписали из роддома. Когда ему стало хуже, няня вызвала скорую, но ребенок умер. Приехавшая полиция не стала разбираться в деталях: детей тут же изъяли и завели дело о торговле детьми. Очевидно, что это дело развалится, поскольку нет ничего, что противоречило бы законодательству РФ. Изъятых детей было трое, из разных семей. Один из родителей оказался отцом-одиночкой, который хотел завести ребенка с помощью суррогатной матери, что, опять же, разрешено российским законодательством. В итоге арестовали врачей, делавших ЭКО, и даже пенсионерку-курьера, а детей отдали в детский дом, да еще и не в обычный, а в "специализированный". Соответственно, дети уже получили тяжелейшую травму и вырастут травмированными. Их родители пишут письма в российские комитеты защиты детей, но все бесполезно. Таково карающее российское правосудие, пожирающее детей.
– Вам кто-нибудь скажет: а не получат ли эти дети психологическую травму, когда узнают, что появились на свет в утробе суррогатной матери?
– Дети воспринимают ситуацию так, как ее преподносят взрослые. Когда взрослые стыдятся или стесняются, дети тоже теряют уверенность. В моей книге есть пример: Валентина Менессон, юная француженка, беседует с психологом. Валентина родилась с помощью яйцеклетки донора, а выносила ее суррогатная мать, поскольку та женщина, которую она считает матерью, не может ни производить яйцеклетки, ни вынашивать. Психолог спросил девочку: у тебя три мамы? Она ответила: нет, одна. Мама – это та, кто считает меня дочерью. Кто был со мной с детства, кто укладывал меня спать, кто заботился, когда я болела, кто учил меня читать, кто делал со мной домашние задания, кто жил со мной. У меня не три мамы, у меня мама с заболеванием матки, прибегнувшая к помощи других женщин. После разговора с Валентиной психолог констатировал, что мир девочки гармоничен, в нем все находится на своих местах, она не травмированный ребенок, а счастливый человек, окруженный любящими людьми.
– В книге много говорится об однополых парах и их попытках завести детей. Где и как они могут это сделать, в каких странах это легко, в каких тяжело и что в России?
В России никто не будет спрашивать у женщины, покупающей донорскую сперму, о ее сексуальности
– Есть страны, которые признают однополые браки. В Швеции или Великобритании страховка на ЭКО распространяется одинаково, там бесплатно можно получить процедуру по квоте, и совершенно неважно, однополая или разнополая пара. В России есть страховка ОМС, но, разумеется, однополая пара не может на нее претендовать. При этом в России никто не будет спрашивать у женщины, покупающей донорскую сперму, о ее сексуальности. Поэтому лесбийские пары могут спокойно завести ребенка таким способом. Мужчина с любой сексуальностью тоже может прийти в клинику, купить яйцеклетку, взять суррогатную мать. Но, учитывая вышеописанные случаи с филиппинцами, люди сегодня предпочитают не рисковать и не делать ЭКО в России.
– Вы говорите: "может прийти в клинику, взять клетку". Но это недешевое удовольствие. Иногда, в Америке особенно, цены на ЭКО превышают возможности скромных людей. Где дешевле, где проще и где дороже всего?
– Дороже всего в Америке – это правда. Мои ровесницы-американки брали контакты моего репродуктолога и говорили: "Мы приедем замораживать яйцеклетки в Россию". В России криоконсервация стоит тысячу долларов плюс-минус, а в Америке – порядка 25 тысяч долларов. Во Франции вообще нельзя заморозить яйцеклетки без медпоказаний, просто чтобы сохранить их на будущее, потому что считается, что процедура вредит здоровью. Ты должна болеть раком, чтобы иметь право заморозить яйцеклетки. Криоконсервация дешевле всего в России, Украине, Грузии. Есть много стран, где ЭКО делают по страховке (в их числе и Россия, но, скажу по собственному опыту, страховку в России получить очень трудно). Страна-идеал в плане страховки – Израиль: государство оплатит женщине сколько угодно попыток ЭКО, пока у нее не родится двое детей. Израиль – одна из передовых стран в плане ЭКО. И еще Швеция, где доступ к страховке может получить одинокая женщина (в России в страховку обязательно должен быть вписан партнер).
– Есть еще одна проблема: люди из более богатых стран эксплуатируют суррогатных матерей из бедных стран. Бедные иностранки вынашивают детей для богатых. Выглядит неэтично.
За богатых рожают бедные
– Суррогатное материнство неэтично по своей сути. Это колониальная практика: за богатых рожают бедные. Поэтому страны типа Индии или Таиланда запретили процедуру иностранцам. В моей книге есть пример: беременная суррогатная мать заболевает, ее помещают в хорошую клинику, но врачей волнует только спасение ребенка; сразу после родов ее переводят в дешевую государственную больницу. Были случаи, когда суррогатные матери подписывали документы, что в случае смерти их мозга они разрешают подключить тело к аппарату для сохранения плода. Суррогатное материнство – очень сложная тема, здесь каждый решает сам. Я знаю женщин, которые никогда не возьмут суррогатную мать, чтобы не подвергать здоровье другого человека риску. Другое дело, что земные блага распределены неравномерно. Деньги, которые суррогатная мать получает за свой труд, она больше нигде не заработает. На эти деньги женщины отдают детей в университеты, делают ремонты, начинают бизнес. Это единственный способ, другого нет.
– Традиционная семья рухнула или все-таки пока это зыбь на воде?
– Пока это проблемы меньшинства. Подавляющее большинство, как из стихотворения Евтушенко, пока что продолжит размножаться традиционным способом.
– Благодаря вашей книге я узнал, как много внимания уделяет этой теме кинематограф, сколько сюжетных коллизий, связанных с бесплодием и репродуктивными техниками. Какие фильмы вы бы посоветовали тем, кто интересуется этой темой?
Доноры подписывают соглашение, где либо подтверждают, либо отрицают свою готовность общаться в будущем
– Фильм Тамары Дженкенс "Частная жизнь", с Полом Джаматти и Кэтрин Хан, играющими богемную пару, живущую на Манхэттене; он театральный режиссер, она писательница, им примерно сорок пять, и тут они подумали: а не завести ли ребенка? Они наконец-то успешны и наконец-то готовы, но ничего не выходит. Этот фильм очень реалистичный. Другие фильмы, которые я упоминаю в книге, – комедии: американцы и британцы обожают шутить про перепутанные пробирки. А самый удачный фильм на эту тему, по-моему, это "Детки в порядке" Лизы Холоденко. У лесбийской пары, которых играют Аннет Беннинг и Джулиана Мур, двое взрослых детей, им скоро 18 и они собираются написать своему донору (Марк Руффало) письмо с предложением встретиться (в большинстве стран донорство неанонимное, поскольку с появлением генетических тестов найти донора стало несложно. Поэтому доноры подписывают соглашение, где либо подтверждают, либо отрицают свою готовность общаться в будущем). Вы спрашивали меня, а как к этой ситуации относятся дети? Ответ – в этом фильме. Дети принимают все гораздо трезвее, у них нет психологических проблем, возникающих у взрослых, выросших с совершенно другими установками в другой среде. Новый мир принадлежит таким детям.
– Инна, вы в конце книги выражаете благодарность не только тем, кто непосредственно помогал вам над ней работать, но и Вирджинии Вулф и Патриции Хайсмит. Почему?
– Талантливые бунтарки, жившие по собственным законам и правилам, дорого за это заплатившие, но показавшие другим пример неповиновения.